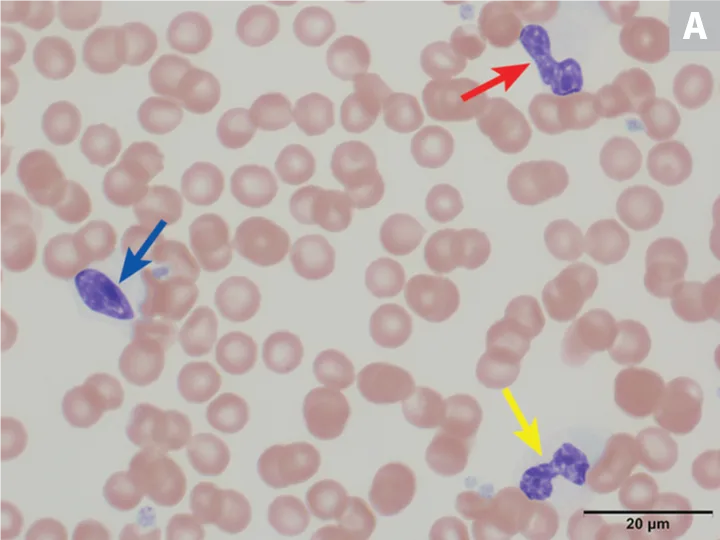
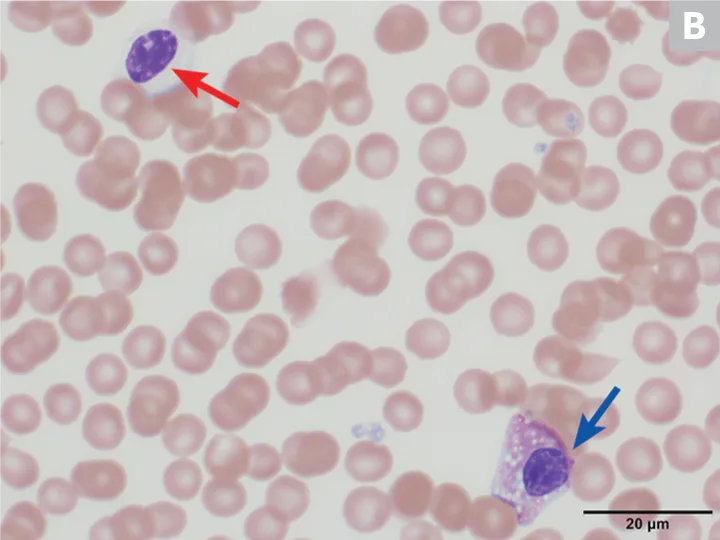
Featured Image
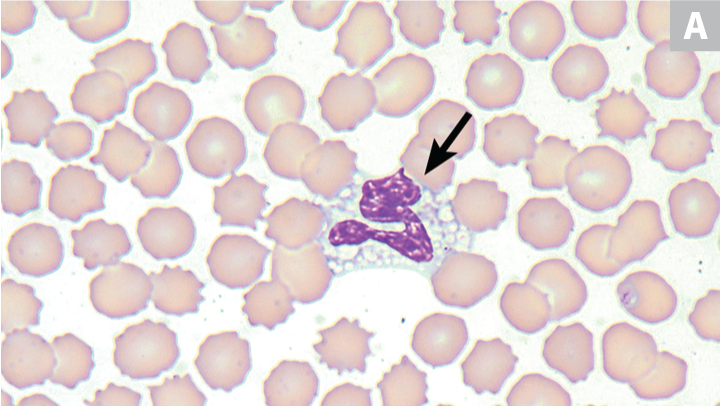
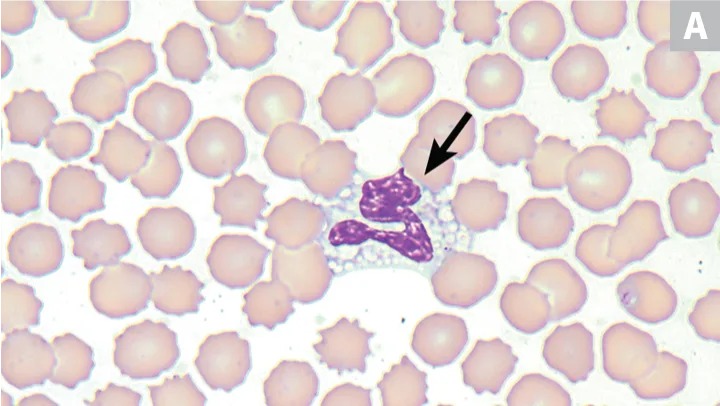
Featured Image
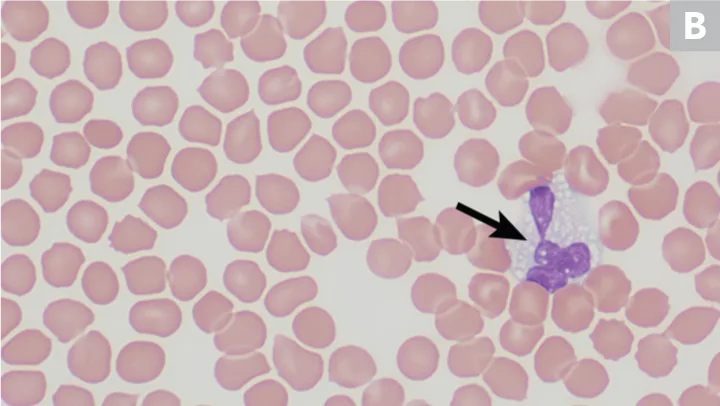
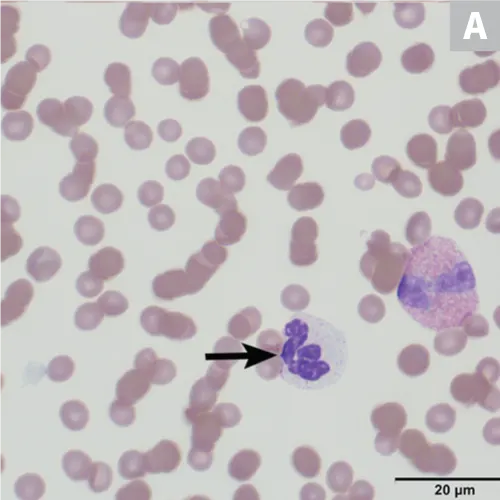
Featured Image
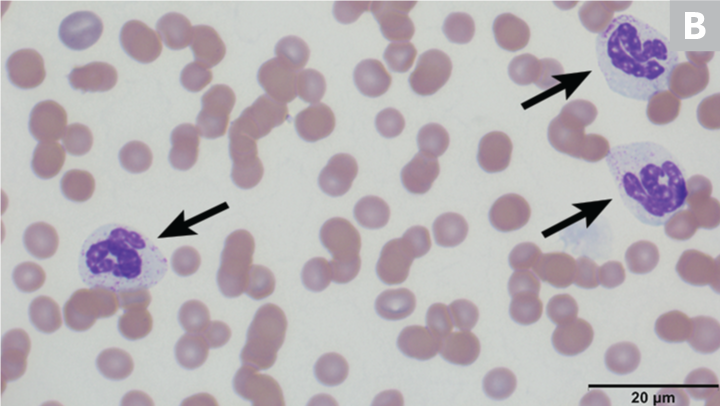
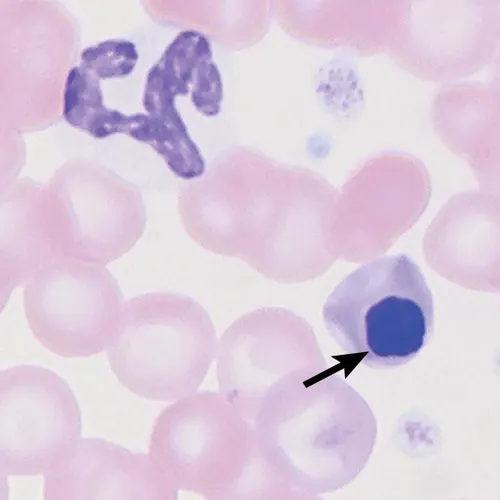
Featured Image

Top 5 Breed-Associated Hematologic Abnormalities
Heather A. Kridel, DVM, DACVP (Clinical), IVG Hospitals by Ethos, Woburn, Massachussetts
Hematologic evaluation via CBC—including automated analysis and manual blood smear evaluation—is routine for wellness health screening and diagnostic evaluation in clinically ill patients. Observed abnormalities typically indicate an underlying disease process; however, many breed-associated hematologic anomalies are not associated with clinical disease. These takeways are important to avoid misdiagnosis of pathologic disease processes.
1. Inherited Macrothrombocytopenia in Cavalier King Charles Spaniels
Autosomally inherited macrothrombocytopenia is common in Cavalier King Charles spaniels.1 One study reported either homozygous or heterozygous mutations in the gene that encodes ß1-tubulin in 81/100 Cavalier King Charles spaniels.1 Affected (ie, homozygous) dogs typically exhibit a decreased total platelet count ranging from 30 000 to 100 000/µL; carrier (ie, heterozygous) dogs exhibit a platelet count from ˜100 000 to 250 000 (range, 200 000-500 000/µL).2 Thrombocytopenia in heterozygous and homozygous dogs, however, is not associated with clinical bleeding, likely because the platelet function is normal and total platelet mass (ie, plateletcrit) is not decreased.2,3
Macrothrombocytes are platelets that are as large as or larger than erythrocytes in diameter (Figure 1).2 Because automated hematology analyzers that use impedance technology cannot distinguish these large platelets from erythrocytes, the automated platelet count may be much lower than the actual count. Performing a platelet count via hemocytometer or a platelet estimate on a blood smear may be more accurate for evaluation of true platelet count. It is important to recognize this breed-associated abnormality so these patients are not presumed to have thrombocytopenia associated with more severe underlying disease (eg, immune-mediated thrombocytopenia).

Peripheral blood smear from a Cavalier King Charles spaniel with macrothrombocytopenia. A macrothrombocyte (arrow) is present among erythrocytes. Wright-Giemsa, 100× original magnification
An identical mutation has been identified in other breeds (eg, English toy spaniel, shih tzu, Maltese, Jack Russell terrier, Havanese, toy poodle, boxer, cocker spaniel, bichon frise, miniature schnauzer, Komondor) and several crossbreed dogs (P. W. Christopherson, DVM, PhD, DACVP, written communication, August 2, 2016). A similar (but separate) mutation has been documented in Norfolk and Cairn terriers4 and in a Jack Russell terrier (P. W. Christopherson, DVM, PhD, DACVP, written communication, August 2, 2016).
2. Pelger-Huët Anomaly in Australian Shepherd Dogs
Pelger-Huët anomaly, an inherited trait resulting in hyposegmentation of the nuclei in mature granulocytes (especially neutrophils), is generally rare and has been reported in humans and various pure- and crossbreed dogs, cats, horses, and rabbits; there is a 9.8% incidence reported in Australian shepherd dogs,5,6 in which the anomaly is transmitted as an autosomal dominant trait with incomplete or decreased penetrance.5 In humans, the abnormality is caused by a defect in the lamin B receptor gene6; the same defect is suspected in dogs but has not been confirmed. Heterozygous dogs do not exhibit clinical signs of disease, and there is no indication of alteration in neutrophil function.6 Animals homozygous for this trait can exhibit skeletal deformities and expire in utero or shortly after birth.7
On hematologic examination, this condition is typically an incidental finding that may be mischaracterized as a marked left shift involving a condensed chromatin pattern of granulocytes and no evidence of toxicity. The nuclei may be round; oval; bilobed; or kidney-, band-, or peanut-shaped (Figure 2).8 It is important to differentiate this anomaly from a true left shift caused by inflammation or infection, in which the left-shifted neutrophil line may exhibit coarse but less clumped chromatin and likely toxic changes, often along with neutropenia or neutrophilia. A pseudo-Pelger–Huët anomaly, also characterized by neutrophil hyposegmentation, may occur in myeloid neoplasms or with administration of certain drugs (rare).8

(A) Peripheral blood from an Australian shepherd dog with Pelger-Huët anomaly. Three neutrophils with condensed chromatin that exhibit band-shape (red arrow), oval (blue arrow), and bilobed or dumbbell-shape (yellow arrow) nuclei. (B) Peripheral blood from an Australian shepherd dog with Pelger-Huët anomaly. One neutrophil with an oval nucleus (red arrow) and one eosinophil with a round nucleus (blue arrow); both exhibit clumped chromatin. Wright-Giemsa, 100× original magnification. Image courtesy of Francisco Conrado and Jennifer Owen, University of Florida
3. Vacuolated or Grey Eosinophils in Greyhounds
Greyhounds are known to have multiple clinicopathologic abnormalities; however, among the most visually interesting is the presence of vacuolated (or grey) eosinophils (Figure 3). One study evaluating greyhounds (n = 49) and nongreyhound dogs (n = 200) found grey eosinophils in 53% of greyhounds using Wright stain as compared with only 1% of nongreyhound dogs; 85% of greyhounds that showed normal eosinophils on Wright-stained smears showed grey eosinophils on Romanowsky stain.9 No ultrastructural or cytochemical differences between grey and normal eosinophils have been demonstrated, and greyhound eosinophils have been shown to be fully functional.9
In another study, grey eosinophils were observed in a group of sighthounds, including greyhounds (45%), Italian greyhounds (34.5%), and whippets (62.5%).10 This study also determined that some hematology analyzers may underestimate or cannot detect the presence of grey eosinophils; however, the underestimation was typically slight and not clinically significant.10 Grey eosinophils may be more frequently observed on Romanowsky stain; they should not be mistaken for toxic neutrophils on blood film evaluation.

Peripheral blood from 2 greyhounds with grey or vacuolated eosinophils; one eosinophil (arrows) is observed in each image. Wright-Giemsa, 100× original magnification. Images courtesy of (A) Luca Giori, University of Tennessee, and (B) Francisco Conrado and Mary Lessinger, University of Florida
4. Neutrophil Granulation in Birman Cats
A hereditary anomaly resulting in abnormal neutrophil granulation has been reported in Birman cats (Figure 4).11 This anomaly is an autosomal recessive trait that results in fine eosinophilic (sometimes reddish) granules within the neutrophil cytoplasm. The granules have normal ultrastructure when evaluated by electron microscopy; the neutrophils exhibit normal function.11 Similar eosinophilic or reddish granulation has also been observed in neutrophils of some Siamese and Himalayan cats.8 The cause of these granules must be differentiated from toxic granulation and lysosomal storage diseases (eg, mucopolysaccharidosis type VI, mucopolysaccharidosis type VII, GM2-gangliosidosis).

(A) Peripheral blood from a Birman cat. A neutrophil with reddish granulation (arrow) is present to the left of the eosinophil. (B) Peripheral blood from a Birman cat. Three neutrophils with reddish granulation are present (arrows). Wright-Giemsa, 100× original magnification. Image courtesy of Francisco Conrado and Jennifer Owen, University of Florida
5. Macrocytosis in Poodles
Poodle macrocytosis is a familial hematopoietic defect that primarily affects toy and miniature poodles. Affected dogs exhibit marked macrocytosis with mean cell volumes between 85 and 105 fL (reference range, 60-77 fL).12,13 Affected dogs do not exhibit clinical signs, anemia, or reticulocytosis; however, metarubricytosis is often observed (Figure 5) with variable features of dyserythropoiesis (eg, nuclear-cytoplasmic asynchrony). Howell-Jolly bodies tend to be increased in number and may be large; multiple Howell-Jolly bodies may be present in a single erythrocyte. Features of dyserythropoiesis can also be observed on bone marrow evaluation and resemble features associated with B12 (ie, cobalamin) deficiency; dogs affected by poodle macrocytosis are not B12-deficient.12,14,15 Poodle macrocytosis should be differentiated from other causes of macrocytosis (eg, strongly regenerative anemia, artifactual increase in MCV caused by erythrocyte agglutination).
Peripheral blood from a miniature poodle with macrocytosis. A metarubricyte is present (arrow); no polychromasia is observed to indicate a regenerative anemia. A few platelets are also present. Wright-Giemsa, 100× original magnification
Conclusion
These breed-associated anomalies result in hematologic abnormalities detected either via automated hematology analyzer or manual blood smear evaluation. Because certain abnormalities may be missed when using only a single evaluation method, both should be performed in conjunction for complete hematologic evaluation. These abnormalities may raise concern or be mistaken for pathologic disease processes; therefore, awareness of breed-associated anomalies is essential when performing hematologic evaluation.